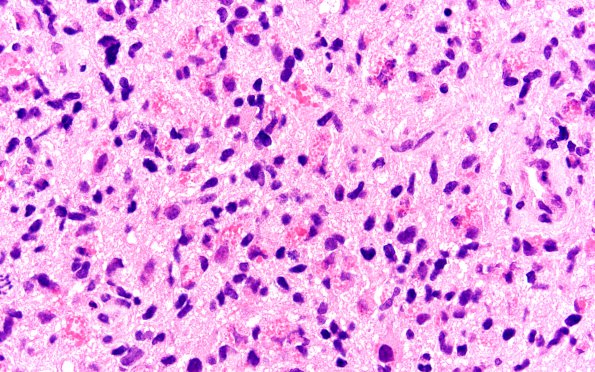
3A7 Glioblastoma, granular cell type (Case 3) FS 60X

Table of Contents
Washington University Experience | NEOPLASMS (GLIAL) | Glioblastoma, granular cell type | 3A7 Glioblastoma, granular cell type (Case 3) FS 60X
A large number of neoplastic cells have abundant cytoplasm packed with eosinophilic granules.